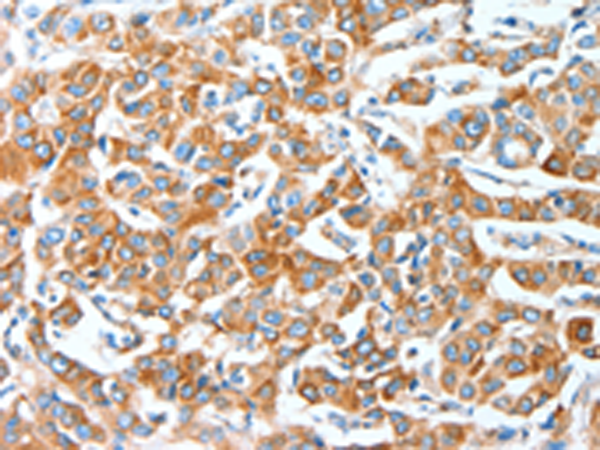

中文名稱: 兔抗AFAP1多克隆抗體
|
Background: |
The protein encoded by this gene is a Src binding partner. It may represent a potential modulator of actin filament integrity in response to cellular signals, and may function as an adaptor protein by linking Src family members and/or other signaling proteins to actin filaments. Multiple transcript variants encoding different isoforms have been found for this gene. |
|
Applications: |
ELISA, WB, IHC |
|
Name of antibody: |
AFAP1 |
|
Immunogen: |
Fusion protein of human AFAP1 |
|
Full name: |
Actin filament associated protein 1 |
|
Synonyms: |
AFAP; AFAP110; AFAP-110 |
|
SwissProt: |
Q8N556 |
|
ELISA Recommended dilution: |
1000-2000 |
|
IHC positive control: |
Human breast cancer and human esophagus cancer |
|
IHC Recommend dilution: |
25-100 |
|
WB Predicted band size: |
81 kDa |
|
WB Positive control: |
A172 cells |
|
WB Recommended dilution: |
200-1000 |

購物車
購物車 幫助
幫助
 021-54845833/15800441009
021-54845833/15800441009
